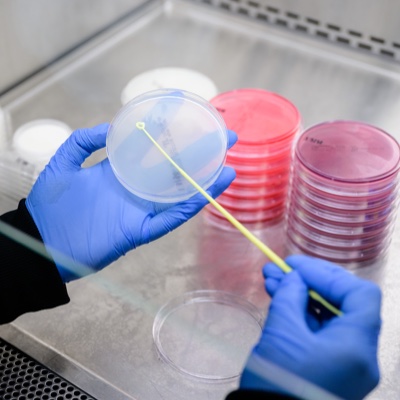

Three campuses. One culture.

300,000 sq. ft. of production and warehousing space.
Watsonville, CA
Our two Watsonville facilities are located approximately 80 miles south of San Francisco and 15 miles south of Santa Cruz.
Headquarters Campus
- 70,000 sq. ft. of production and warehousing facilities
- Corporate offices
- R&D and QA/QC lab
- Production focus: Liquids, Hot Pour
Anhydrous Campus
- 80,000 sq. ft. of production and warehousing facilities
- Production focus: Anhydrous products
Prescott, WI
Our Prescott facility is located approximately 30 miles from the center of Minneapolis and 25 miles from MSP airport.
- 165,000 sq. ft. of production and warehousing facilities
- Administrative offices
- R&D and QA/QC lab
- Production focus: Liquids, Hot Pour